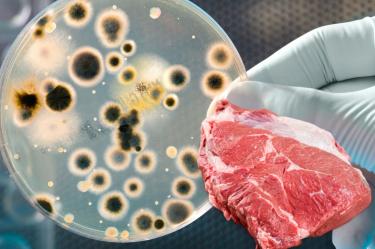
thumb

Síntomas de Vibrio Vulnificus; la bacteria carnívora que vive en el mar
La infección por Vibrio vulnificus avanza rápido y puede ser mortal. Conoce sus síntomas, vías de contagio y factores de riesgo para prevenirla.
La frase “bacteria carnívora” no es exageración. Los síntomas de Vibrio vulnificus pueden evolucionar de fiebre a necrosis en horas, dejando poco margen para actuar.
Según los Centros para el Control y la Prevención de Enfermedades (CDC), esta bacteria marina se asocia a casos graves de septicemia y heridas infectadas, con una tasa de mortalidad que puede superar el 30 % en pacientes vulnerables.
¿Qué es Vibrio vulnificus y dónde se encuentra?
Vibrio vulnificus es una bacteria gramnegativa presente en aguas marinas cálidas y salobres. Su hábitat natural incluye costas, estuarios y mariscos crudos o mal cocidos, especialmente ostras.
De acuerdo con la Cleveland Clinic, la infección suele presentarse en dos escenarios:
- Por ingestión: al consumir mariscos contaminados.
- Por contacto: cuando una herida abierta entra en contacto con agua o animales marinos infectados.
- El riesgo aumenta en los meses de verano, cuando la temperatura del agua favorece su proliferación.

También te puede interesar: Bacteria carnívora suma 4 muertes y pone en alerta a Florida
Síntomas iniciales de la bacteria Vibrio vulnificus
Los síntomas dependen de la vía de entrada del patógeno. Sin embargo, suelen aparecer entre 12 y 72 horas después de la exposición.
Por ingestión (gastrointestinal):
- Fiebre y escalofríos
- Dolor abdominal intenso
- Diarrea acuosa, a veces con sangre
- Náuseas y vómitos
Por contacto con heridas:
- Enrojecimiento e hinchazón en la zona afectada
- Dolor desproporcionado respecto a la apariencia inicial
- Ampollas o úlceras que se expanden rápidamente
- Cambios de coloración (piel púrpura o negra) por necrosis
En infecciones graves puede desarrollarse septicemia con hipotensión, fallo multiorgánico y, en casos extremos, la muerte en menos de 48 horas.

También te puede interesar: Hombre sobrevive a la 'bacteria carnívora'; fue mordido por su pariente
¿Por qué se le llama “bacteria carnívora”?
El apodo se debe a que Vibrio vulnificus puede causar fascitis necrosante, una destrucción rápida del tejido subcutáneo y muscular. Aunque este fenómeno no implica que la bacteria “coma” la carne, la infección desencadena una respuesta inflamatoria que destruye el tejido y requiere intervención quirúrgica urgente.
Según el Centre for Health Protection (CHP) de Hong Kong, la tasa de amputaciones en infecciones avanzadas puede ser alta debido a la rapidez con la que el daño se propaga (CHP).

También te puede interesar: Bacteria carnívora de playa casi le cuesta la vida a joven
Factores de riesgo y grupos vulnerables
No todas las personas expuestas desarrollan enfermedad grave, pero el riesgo aumenta en:
- Personas con enfermedades hepáticas crónicas
- Pacientes inmunodeprimidos
- Adultos mayores
- Personas con diabetes
- Individuos con heridas expuestas a agua de mar o mariscos crudos
La prevención es especialmente crítica para estos grupos, pues la evolución clínica puede ser fulminante.
¿Cómo prevenir la infección por Vibrio vulnificus?
Medidas recomendadas por el CDC y la Cleveland Clinic:
- Evitar consumir mariscos crudos, especialmente ostras.
- Cocinar bien todos los productos marinos.
- Usar guantes al manipular mariscos crudos.
- No exponer heridas abiertas a agua salada o salobre.
- Limpiar inmediatamente cualquier corte o raspadura que haya estado en contacto con el mar.
Tratamiento y pronóstico
El tratamiento debe iniciarse de forma inmediata. Incluye:
- Antibióticos de amplio espectro (por ejemplo, doxiciclina y ceftriaxona).
- Desbridamiento quirúrgico del tejido infectado.
- Terapia intensiva en casos de septicemia.
Cuanto más rápido se intervenga, mejores son las probabilidades de supervivencia. Retrasar la atención puede ser letal.
Preguntas frecuentes
- ¿Es común infectarse con Vibrio vulnificus? No, es poco frecuente, pero los casos graves suelen tener alta mortalidad.
- ¿Se puede contraer en piscinas o agua dulce? No, esta bacteria vive en agua salada o salobre.
- ¿Los síntomas siempre incluyen necrosis? No, pero la necrosis puede aparecer rápidamente en infecciones de heridas graves.
- ¿Un sistema inmune sano puede defenderse? En la mayoría de los casos leves, sí; pero aun en personas sanas, la infección puede complicarse.
Vibrio vulnificus es un recordatorio de que la naturaleza tiene armas invisibles y letales. No se trata de vivir con miedo al mar, sino de respetar sus riesgos. Cocinar bien los mariscos y proteger cualquier herida antes de entrar al agua puede marcar la diferencia entre unas vacaciones inolvidables y una emergencia médica.
Y ante el menor síntoma, la regla es clara: buscar atención médica de inmediato. Porque con esta bacteria, cada hora cuenta.